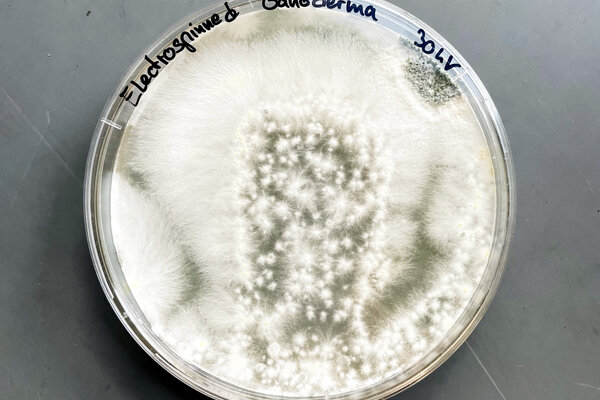

A wide spectrum of areas of practice are open to industrial designers today: from the development of real products to the design of processes, interactions and programmes. This activity could be in the conceptual design of plans of action, communications strategies or services, or in the design of physical or digital products. The aim of the course – as demonstrated by the master’s thesis – is the attainment of a high degree of skill and originality in conception and design along with the ability to develop holistic, integrated design strategies, combined with critical reflection on the societal, cultural, scientific, technological, economic and ecological conditions and choices that apply to the design task in question.
Teaching content
In research and teaching as part of a university master’s course, design as a “method of interventon” and a “tool for innovation” takes into account the latest technological developments as well as scientific knowledge about humans in their natural and social surroundings. The project-oriented master’s course trains students in the methodical planning and implementation of cross-disciplinary design processes and in the team and communications skills required here. The ability to select from among various projects – including cross-course projects – offers students an opportunity for detailed development of individual standpoints. Cooperations with other universities, research bodies and partners from industry and the arts round off this course of study.
Standard duration of course
The duration of the master’s course is dependent on its type and contents and also on the duration of the preceding completed course or the ECTS points achieved in the preceding course; the duration is generally between two and four semesters.
Course of study
In the final semester, students work on a master’s thesis on an individual design topic. The preceding semesters focus on project studies, which can be supplemented by diverse course elements from module areas in design studies or related subjects.
Prerequisites
The master’s courses are aimed at graduates with a bachelor’s or a ‘Diplom’ degree with an artistic/design emphasis. However, interested graduates of other disciplines who have relevant qualifications may also be admitted to a master’s course after taking the course-specific entrance test.
Occupational field
The Industrial Design master’s course prepares graduates for a variety of areas of activity and provides ideal prerequisites for starting a freelance design and consultancy career or for carrying out important tasks with significant levels of responsibility in companies or other institutions.
Degree
Master of Arts (M.A.)